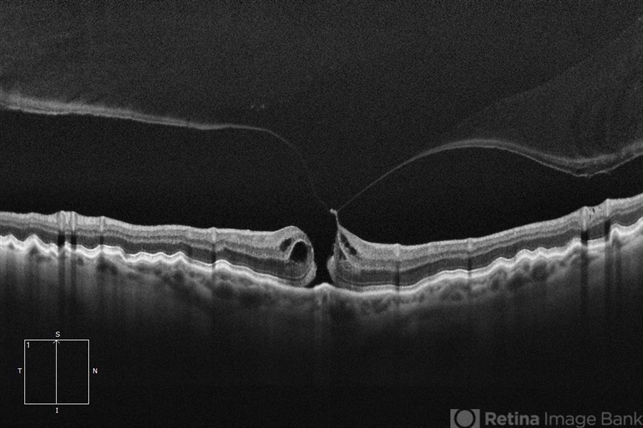
file

-
 By Drew Mitchell
By Drew Mitchell
Retina Associates LLC - Uploaded on Mar 21, 2025.
- Last modified by Joshua Friedman on Mar 21, 2025.
- Rating
- Appears in
- OCT Collection
- Condition/keywords
- FTMH, macular hole, PVD, OCT, Choroidal Folds
- Photographer
- Drew Mitchell OCT-C
- Imaging device
-
Optical coherence tomography system
Zeiss Cirrus 6000 - Description
- HD 1 line 100x OCT showcasing a full thickness macular hole caused by vitreomacular traction on fovea. Choroidal folds can also be seen on scan.

Initializing download.
Initializing download.










